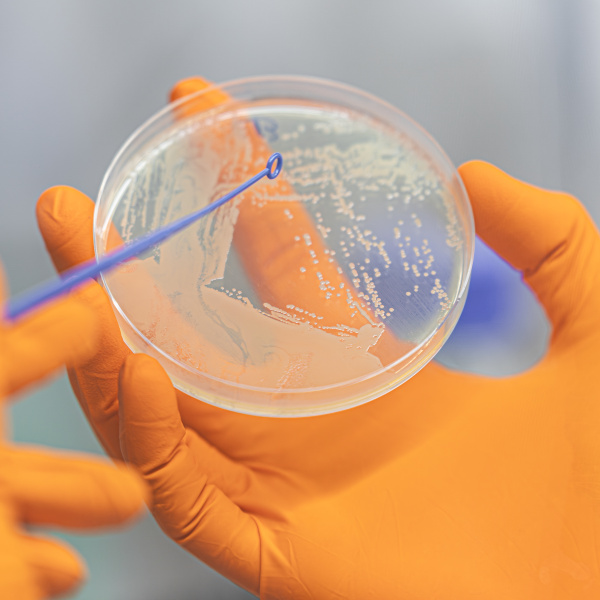

Introducing the Lygature Impact Report
We’re proud to share the first-ever Lygature Impact Report — a milestone in our commitment to advancing healthcare innovation through complex collaborations.
The report applies an externally validated model to assess our impact and features stories that highlight how our partnerships deliver tangible results and contribute to meaningful societal change.
As we continue our mission to shape healthcare innovation through collaboration, we will keep sharing insights into the impact of our work — and the people and projects behind it.
Recent news
Our value proposition
Accelerating the development of new medical solutions for patients
Lygature aims to accelerate the development of new medical solutions for patients by driving public-private collaboration between academia, industry and society. We are a not-for-profit organization that enables, drives and supports partnerships to address unmet medical needs.
-
Creating a safe space for innovation
-
Driving the partnership forward to deliver medical solutions
-
Providing specialized support for partnerships